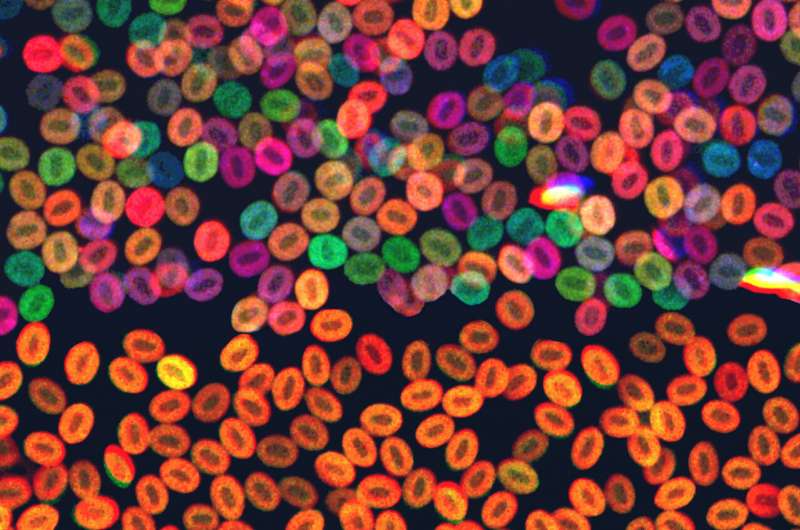
血细胞.jpg

通过防止血细胞接管来预防白血病
发布日期:2021-11-14斑马鱼外周血中的斑马鱼红细胞,具有不同血细胞谱系的正常鱼显示在顶部,而具有克隆造血功能的突变斑马鱼显示在底部。波士顿儿童医院 Zon 实验室的 Jonathan Henninger 博士和 Serine Avagyan 医学博士说到。
随着年龄的增长,我们中的许多人会发生突变,导致我们的一些造血干细胞比其他干细胞繁殖得更快,形成自己独特的群体或“克隆”。这被称为克隆性造血。在某些情况下,源自单个基因改变或突变的干细胞的单个克隆可以扩展到构成一个人血细胞的 30%。
如果这种“流氓”克隆获得更多突变,就会导致骨髓增生异常(一种罕见的血液病),进而导致白血病。波士顿儿童医院干细胞研究项目主任、医学博士伦纳德·佐恩 (Leonard Zon) 的实验室想知道是否可以将这些流氓种群扼杀在萌芽状态,从而防止可能致命的白血病发生。
如果是这样,它可以帮助随着年龄增长而发生克隆性造血的成年人和患有各种血液疾病的儿童,如 Shwachman-Diamond 综合征、GATA2 缺乏症或 RUNX1 家族性血小板疾病,其中克隆性造血可以在儿童时期发展。
“这些孩子有种系突变,使他们在生命早期就有患白血病的风险,”丹娜法伯/波士顿儿童癌症和血液疾病中心的儿科肿瘤学家、医学博士 Serine Avagyan 解释说。 Zon 实验室。“他们可以在青春期,有时在更年轻的时候发生克隆性造血。我们认为这些易感综合征加速了克隆性造血的过程,导致了早发性白血病。”
人们假设某些干细胞群体变得占主导地位——并最终致癌,因为它们通过基因突变获得了某种优势。或者,正如查尔斯·达尔文所说,他们变得更加“健康”。“如果你能理解造血干细胞的克隆是如何发生癌变的,你就可以专门针对导致问题的有问题的克隆,”Zon 说。





